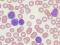
Imágen noticia

|
|
|
|
|
|
|
|
|
|
|
|
|
|
|
|
|
|
|
|
|
|
|
|
|
|
Ultimas noticias
LIBROS
 20/12/2009
20/12/2009 LANZAN EL LIBRO “EL LABERINTO DE LOS CELOS”. La autora Lucy Romero, mujer polifacética; psicóloga, instructora de meditación, conferencista, e ... Ver más |  18/12/2009
18/12/2009100 AÑOS VELANDO POR LA SALUD DE LA POBLACIÓN DEL DISTRITO FEDERAL La Secretaría de Salud de GDF y Bayer Schering Pharma presentaron el libro conmemorativo “Cien Años atendiendo a tu salud” Ver más  15/12/2009
15/12/2009EL TESTIMONIO DE LA PASIÓN ALBIVERDE, PLASMADO EN UN LIBRO. TSM, La Nueva Era”, en cuyas páginas describen los momentos más importantes en la historia de Santos Laguna y la transición al Territorio Santos Modelo. Ver más |
Copyright © 2026 Reseña Digital - Visitantes: 57,808,048
PORTADA | FAVORITOS | RSS | CONTACTO | BUSCAR | IMPRIMIR
ESPECTÁCULOS TURISMO CINE. TV Y DVD SEGURIDAD TECNOLOGÍA INSTITUCIONES RESP. SOCIAL LIBROS EVENTOS ESPECIALES EXPOS Y FERIAS DEPORTES MODA Y BELLEZA AVANCES MÉDICOS
Sitio Web diseñado por EspacioMéxico
PORTADA | FAVORITOS | RSS | CONTACTO | BUSCAR | IMPRIMIR
ESPECTÁCULOS TURISMO CINE. TV Y DVD SEGURIDAD TECNOLOGÍA INSTITUCIONES RESP. SOCIAL LIBROS EVENTOS ESPECIALES EXPOS Y FERIAS DEPORTES MODA Y BELLEZA AVANCES MÉDICOS
Sitio Web diseñado por EspacioMéxico